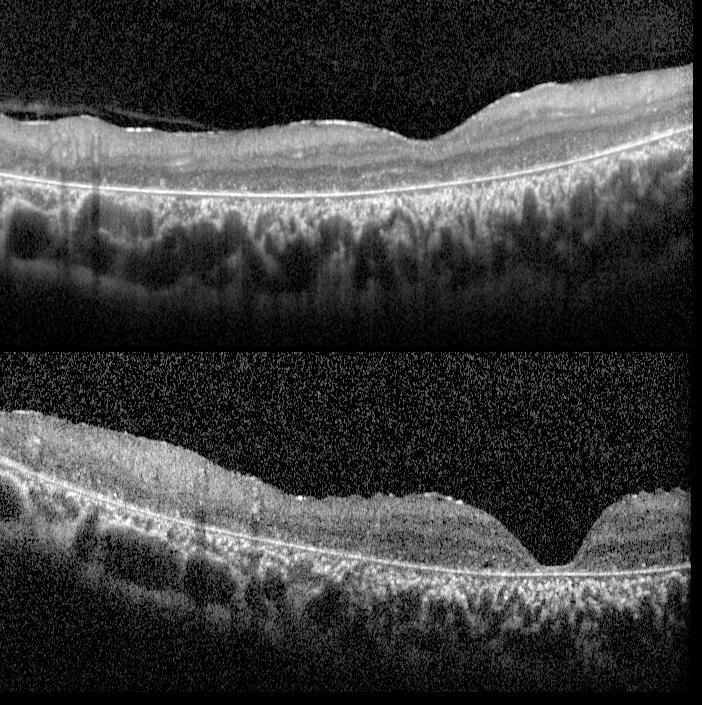

18-year-old girl with severe ABCA-4 retinopathy presenting with cone-rod dystrophy features. Both eyes had Visual acuity of 20/1600 (2 m CF).
In color fundus photography, bone spicules, and arterial narrowing were present at the posterior pole. The fixation point was located eccentrically upwards (color photography).
Color fundus photographs of severe ABCA-4 retinopathy


Autofluorescence imaging showed peripapillary sparing in addition to central hypoautofluorescence lesions and ring-like hyperautofluorescence at the outer edge of these lesions. There were also some hypoautofluorescence lesions in the mid periphery but no fleck retinopathy appeared.
Autofluorescence images of severe ABCA-4 retinopathy





OCT showed severe photoreceptor and RPE atrophy.
OCT of severe ABCA-4 retinopathy
Infra-red reflectance images did not provide any specific features of disease.
Infra-red reflectance image of severe ABCA-4 retinopathy


The genetic test revealed an autosomal recessive, frameshift mutation in the ABCA-4 gene, resulting in complete loss of the ABCA-4 protein function. Although the ABCA-4 gene is known as the Stargardt gene, severe AR defects in the ABCA-4 gene can cause cone-rod dystrophy. These patients can also have some features of Stargardt disease. It would be more accurate to name such diseases with the relevant genes rather than specific names: ABCA-4 retinopathy
Credit: M. Giray Ersoz, MD, FEBO
Biruni University School of Medicine, Department of Ophthalmology, Istanbul, Turkey
Instagram accounts: @retina.review and @retina.dr.girayersoz


